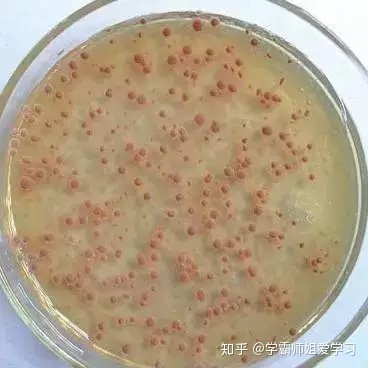

level 7
作者:学霸师姐爱学习
链接:https://zhuanlan.zhihu.com/p/62053191
来源:知乎
著作权归作者所有。商业转载请联系作者获得授权,非商业转载请注明出处。
另外2020高考临近,为了帮助大家更好提升成绩,师姐在文末为大家准备了提分干货,
话不多说,直接给大家上干货!
1.植物细胞的储能物质主要是淀粉、脂肪,动物细胞的储能物质主要是糖原和脂肪。区分直接能源、主要能源、储备能源、根本能源。
2.蛋白质的基本元素是C、H、O、N,S是其特征元素;核酸的基本元素是C、H、O、N、P,P是其特征元;血红蛋白的元素是C、H、O、N、Fe,叶绿素的元素是C、H、O、N、Mg;不含矿质元素的是糖类和脂肪。
3.原核细胞的特点有①无核膜、核仁②无染色体③仅有核糖体④细胞壁成分是肽聚糖⑤遗传不遵循三大规律⑥仅有的可遗传变异是基因突变⑦无生物膜系统⑧基因结构编码区连续
4.内质网是生物膜系统的中心,外与细胞膜相连,内与外层核膜相连,还与线粒体外膜相连。对蛋白质进行折叠、组装、加糖基等加工,再形成具膜小泡运输到高尔基体,进一步加工和分泌。
5.分泌蛋白有抗体、干扰素(糖蛋白)、消化酶原、胰岛素、生长激素。经过的膜性细胞结构有内质网、高尔基体和细胞膜。
6.三种细胞分裂中核基因都要先复制再平分,而质基因都是随机、不均等分配。只有真核生物才分成细胞核遗传和细胞质遗传两种方式。细胞的生命历程是未分化、分化、衰老、死亡。分裂次数越多的细胞表明其寿命越长。细胞衰老是外因和内因共同作用的结果。
7.细胞分化的实质是基因的选择性表达,是在转录水平调控的。
8.细胞全能性是指已分化的的细胞具有发育成顽症个体的潜能。根据动物细胞全能性大小,可分为全能性细胞(如动物早期胚胎细胞),多能性(如原肠胚细胞),专能性(如造血干细胞);根据植物细胞表达全能性大小排列是:受精卵、生殖细胞、体细胞;全能性的物质基础是细胞内含有本物种全套遗传物质。
9.影响酶促反应速度的因素有酶浓度、底物浓度、温度、酸碱度等。使酶变性的因素是强酸、强碱、高温。恒温动物体内酶的活性不受外界温度影响。α-淀粉酶的最适温度是60度左右。
10.基因工程的工具酶是限制性内切酶、DNA连接酶(作用于磷酸二酯键);细胞工程的工具酶是纤维素酶和果胶酶(获得原生质体时需配制适宜浓度的葡萄糖溶液,保证等渗,保护原生质体),胰蛋白酶(动物细胞工程)。
2020年02月18日 15点02分